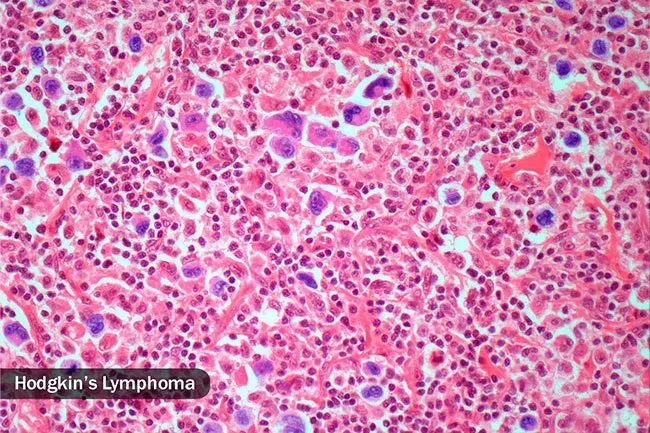

Le Informazioni Presenti Sul Sito Non Costituiscono Consulenza Medica. Non Vendiamo Nulla. L'Accuratezza Della Traduzione Non È Garantita. Disclaimer
MedicamentiCosa causa la sudorazione notturna?
Cosa sono i sudori notturni?

Potresti rompere in un sudore quando la tua stanza si sente calda o hai ammucchiato troppe coperte. Ma non è quello di cui stiamo parlando. Night Sweat si riferisce a ripetute inzuppamento del sudore nel cuore della notte che è probabile che ti svegli e talvolta così tanto che devi cambiare le tue lenzuola. Di solito è correlato a un problema medico. Affrontare tutto ciò che è può alleviare la sudorazione.
Tiroide iperattiva

Sudare di più ed essere sensibili al calore sono notevoli sintomi di ipertiroidismo. La tua ghiandola tiroidea controlla il tuo metabolismo, quindi quando fa troppo ormone il tuo corpo va in overdrive. La temperatura corporea aumenta e potresti essere più affamato o più sete avere un polso da corsa o le mani che stringono le mani e si sente fuori dalla diarrea e perdi peso.
Basso livello di zucchero nel sangue

Hai il diabete? Mentre il tuo glicemia può essere OK quando ci si accende può cadere mentre dormi. Forse hai trascorso una giornata molto attiva o ti sei allenato la sera o hai cenato tardi. Se usi insulina o prendi un farmaco di tipo sulfonilurea per gestire il diabete che potrebbe essere responsabile dell'ipoglicemia durante la notte. Quando il glucosio è inferiore a 140 mg/dl prima di andare a letto o potrebbe cadere in poche ore, fare uno spuntino.
Apnea notturna

Quando hai questa condizione, smetti di respirare ancora e ancora durante la notte. Poiché il tuo corpo non sta ottenendo ossigeno, potrebbe scivolare in modalità combattimento o volo che innesca la sudorazione. Ogni volta che deve iniziare la respirazione significa anche uno scoppio di lavoro dai muscoli. Le persone che usano una macchina CPAP per aiutarli a respirare di notte hanno sudori notturni tutte le volte che quelle che non hanno apnea notturna.
Reflusso acido

Non sono solo il bruciore di stomaco e il dolore al petto che possono svegliarti. GERD non è stato studiato molto come causa di sudorazioni notturne, ma i medici affermano che c'è una possibile connessione. E trattarlo può spesso alleviare la tua sudorazione notturna. Mangia pasti più piccoli e non prima di andare a letto. Evita i cibi trigger, come quelli che sono fritti grassi o a base di pomodoro. Vedi il medico se i sintomi sono gravi o si verificano più di un paio di volte a settimana.
Linfoma
Molti tumori possono causare sudorazioni notturne, ma il più comune è il linfoma che inizia in alcune parti del sistema immunitario del tuo corpo come i linfonodi il midollo osseo della milza e il timo. Circa un quarto delle persone con il linfoma di Hodgkin ottengono sudorazioni notturne e hanno una febbre bassa. Possono anche essere stanchi pruriginosi e dopo aver bevuto alcol fa male dove si trova il loro tumore. Le persone con linfoma aggressivo o avanzato non Hodgkin possono anche avere sudori notturni inquietanti.
Farmaci

Molti droghe possono causare sudorazioni notturne tra cui riduttori della febbre da banco come paracetamolo e FANS come aspirina e ibuprofene. Antidepressivi più anziani chiamati triciclici o TCA, nonché terapia di sostituzione dell'ormone dell'ormone della venlafaxina e steroidi come il cortisone e il prednisone sono sospetti comuni. Alcuni medicinali per il glaucoma e la bocca secca stimolano anche le ghiandole del sudore. Verificare con il farmacista o il medico.
Tubercolosi

Circa la metà di tutte le persone che ricevono questa malattia hanno sudorazione notturna. I batteri di solito crescono nei polmoni. Probabilmente avrai una seria tosse dolorosa con sangue e gunk colorato (Phlegm). Potresti anche sentirti stanco e debole e non avere appetito.
Ansia

La preoccupazione da stress e il panico possono farti scoppiare di sudore durante il giorno, quindi non sorprende che l'ansia possa avere lo stesso effetto di notte. Gli incubi e i terrori del sonno sono meno comuni negli adulti rispetto ai bambini, ma entrambi possono lasciare chiunque sudato e con un cuore martellante. Cerca l'aiuto da un terapista del consulente o dal medico se questi disturbi sono in corso o causano problemi nella tua vita.
HIV

I linfonodi doloranti o gonfi della febbre e il dolore articolare sono sintomi più comuni dopo aver ottenuto il virus e diventare sieropositivo, ma circa 1 su 10 persone ricevono sudorazioni notturne. Le persone che vivono con l'HIV che hanno sintomi come la perdita di peso e la diarrea possono avere sudorazioni notturne una volta alla settimana circa. Le infezioni opportunistiche legate all'AIDS come Mycobacterium avium (Mac Mai) e il citomegalovirus possono causare anche loro.
Tumore

Il carcinoma renale al carcinoma della prostata e alcuni tumori nelle ovaie e nei testicoli (sia cancerosi che non) sono esempi comuni di ciò che i medici chiamano tumori solidi che possono causare sudorazioni notturne. Un tipo di cancro alla tiroide avanzato e cancro nel tuo pancreas potrebbe anche farli scatenarli. I sudori notturni sono un classico sintomo della sindrome carcinoide l'effetto di un raro cancro di solito presente nel sistema digestivo o nei polmoni.
Menopausa

Le vampate di calore prima e dopo il periodo finale possono essere difficili da distinguere dalle sudorazioni notturne. Anche le donne più giovani che hanno rimosso entrambe le ovaie o che hanno smesso di mestruare a causa della chemioterapia possono ottenerle. È più probabile che accada quando sei ansioso depresso o bevi un drink ogni giorno. Ma solo perché sei una donna dell'età giusta (in genere alla fine degli anni '40 o '50) non presumere che le sudorazioni notturne siano legate alla menopausa.
Infezione

Infeziones can trigger night sweats. Some infections like bacterial endocarditis (infection of the inner lining of your heart and heart valves) and osteomyelitis (bone infections) can cause it. There are other more rare infections that can cause night sweats as well and your doctor will check you for them based on your risk factors exposure and travel history.
Feocromocitoma

Questo raro tumore che cresce nelle ghiandole surrenali di solito non è canceroso ma può far sì che il tuo corpo faccia troppi ormoni che aumentano la pressione sanguigna e causano sudori notturni e un polso da corsa. La maggior parte delle persone con un feocromocitoma ha tra 20 e 50 anni. È più probabile che tu lo abbia difficoltà a controllare la pressione alta o hai familiari che hanno avuto uno o un disturbo genetico correlato.
Trova sollievo

Una temperatura più bassa in camera da letto e i ventilatori per far circolare l'aria può renderti più comodo. Usa lenzuola e PJ a asciugatura rapida. Evita tessuti sintetici che non respirano. Se non riesci a capire cosa sta causando le sudorazioni notturne, mantieni un diario da condividere con il tuo medico. Idealmente sarai in grado di trattare la causa e non solo il sintomo.
Cosa causa la sudorazione notturna?
Fonti: 
Immagini fornite da:
- Thinkstock
- Thinkstock
- Thinkstock
- Le immagini Getty
- Thinkstock
- Le immagini Getty
- Thinkstock
- Thinkstock
- Thinkstock
- Thinkstock
- Fonte scientifica
- Le immagini Getty
- Fonte scientifica
- Immagini mediche
- Thinkstock
Riferimenti:
- Uptodate: Approccio al paziente con sudorazione notturna Presentazione clinica e diagnosi di linfoma non hodgkin .
- Mayo Clinic: Night Sweat Malattia del reflusso gastroesofageo (GERD) Linfoma Disturbi dell'ansia Disturbo da incubo Sleep Terrors (Night Terrors) Sindrome carcinoide Pheochromocitoma .
- Harvard Health Publishing: Hai una tiroide iperattiva? Comprensione della risposta allo stress.
- Joslin Diabetes Center: Evitare i minimi notturni.
- Cleveland Clinic: Apnea notturna.
- BMJ Open: Sudorazione notturna - Un sintomo comune di apnea ostruttiva del sonno: la coorte di apnea del sonno islandese.
- Anali di medicina interna: reflusso gastroesofageo come causa di sudorazione notturna.
- Medico di famiglia americano: Diagnosi di sudori notturni.
- Società internazionale di iperidrosi: sudori notturni.
- CDC: 'Tuberculosis (TB): segni
- Scelte del NHS: sudori notturni.
- Dipartimento degli affari dei veterani degli Stati Uniti: Condizioni relative all'HIV: tutta la lezione.
- Aidsinfo: Mycobacterium Avium Complex (Mac) Infezione Mycobacterium avium-intracellulare (MAI) Infezione .
- National CMV Foundation: CMV acquisito: introduzione e sintomi.
Questo strumento non fornisce consulenza medica. Vedere ulteriori informazioni: 
Questo strumento non fornisce consulenza medica. È destinato solo a scopi informativi generali e non affronta circostanze individuali. Non è un sostituto della diagnosi o del trattamento di consulenza medica professionale e non dovrebbe essere invocato per prendere decisioni sulla tua salute. Non ignorare mai la consulenza medica professionale nella ricerca di cure a causa di qualcosa che hai letto sul sito RXLIST. Se ritieni di poter avere un'emergenza medica, chiama immediatamente il medico o componi il 911.
© 1996-2025 WebMD LLC . Tutti i diritti riservati.
